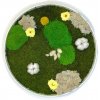

Kruh
Našli sme na Heureka.sk
de Buyer 3098.08 Perform. kruh. rám 20,5cm nerez 3098.08 Perform. kruh. rám 20,5cm nerez
663 - 709 Sk
Omi pulzná magnetoterapia magnetoterapeutický prístroj celotelový matrac + kruh Matrac + kruh
12 924 - 12 954 Sk
de Buyer 3098.05 Perform. kruh. rám 12,5cm nerez 3098.05 Perform. kruh. rám 12,5cm nerez
482 - 612 Sk
|
Nájdených viac ako 1000 záznamov (zobrazujem 361 až 380)
Cena vrátane DPH
|
|||
Dětský kusový koberec Play 105204 kruh 133x133 (průměr) kruh cm |
44,69 € |
||
Kusový koberec Brilliant shaggy 4200 taupe Kruh průměr 120 cmLesklý,hustý,jednobarevný vlas dodává koberci na nadčasovosti,luxusu a eleganci. Brilliant shaggy se pyšní výškou vlasu 5 cm,hustotou vpichů až 61 000. Na dotek jsou velmi příjemné,vhodné především do obývacích prostor. |
46,98 € |
||
Kusový koberec Salsa shaggy 3201 grey Kruh průměr 80 cmKusové koberce Salsa Shaggy jsou novou kolekcí mezi kusovými koberci s hustým dlouhým vlasem pro rok 2021. Vysoký vlas u kusových koberců stále nevychází z módy ani obliby u zákazníků,proto výrobce dalším rokem vsází v jejich odbyt a spokojenost u zákazníka. Kolekce kusových koberců Salsa shaggy s j... |
14,34 € |
||
Najkoberce Berber 7061 Ivory krém Romby 3D, kruh 133 cm kruhVyberte si z našej ponuky kobercov v rôznych farbách, veľkostiach a vzoroch. Vyrobené sú z kvalitných materiálov a nevyžadujú náročnú údržbu. Široká ponuka vám poskytuje možnosť vybrať si koberec, ktorý sa bude hodiť do štýlu interiéru, ktorý máte doma.▪ Výška vlasu: 30 mm▪ Celková hmotnosť: Cca 3,6... |
157,00 € |
||
Kruh listy s menomAkrylový ozdobný zápich vyrobený z materiálu podľa vlastného výberu Farba - výber pri produkte z ponúkaných farieb, tu nájdete Vzorky farieb akryl Veľkosť: Šírka zápichu 12 cm Personalizácia: Vloženie Mena (dátumu) podľa požidavky - Meno (dátum) uvedte do poznámky k produktu pri objednávke Typ z... |
11,50 € |
||
Olivie Strieborné náušnice KRUH GOLD 7938 Ag 925; ≤2 g.STRIEBORNÉ NÁUŠNICE KRUH ROSE - Inovovaný skrutka Sissi - vynikajúca kvalita a ideálna veľkosť! - Zapínanie na skrutku patrí medzi najbezpečnejšie zapínania a zabraňuje strate náušníc. - Osadené číre zirkóny. - Priemer: 10 mm. - Dĺžka tyčinky je 9 mm, z toho skrutkovacia časť má 6 mm a hl... |
60,90 € |
||
Escape kruh 510480 červená Kruh 120 cm průměrČervený kruhový koberec Escape za nízkou cenu se hodí do každých klasických prostor. Vzor koberce sa dá kombinovat s kusovými koberci Escape v mnoha rozměrech. Materiál: 100% polypropylen Výška koberce: 10 mm Váha koberce: 1400 g/m2 |
29,03 € |
||
PANDORA prsteň Nekonečný kruh 192993C06PANDORA prsteň nekonečný kruh so syntetickou perlou. Originálny prsteň k mesiacu narodenia - JÚN. Vďaka jednoduchej obrúčke a drobnému očku je ako stvorený na každodenné nosenie. |
49,00 € |
||
Kruh O150cmKrásny jemne vyšívaný obrus s teflónovou úpravou béžovej farbe kruh 160cm. Zloženie: 100% Polyester Rozmer: kruh 150cm Farba: béžová / jemné vyšitie |
35,87 € |
||
Kusový koberec Calypso 885 anthracite Kruh 160 cm průměrSuper moderní koberce Calypso i pro náročné zákazníky! Kusový koberec Calypso působí nadýchaně. Jejich příjemné barvy a plastický design připomínající bochánky či obláčky se hodí především do moderních prostor. Zaujme především pro jejich jedinečnost,neokoukaný vzhled. Konce střiže jsou lehce zmelír... |
143,36 € |
||
Veselá Stena Samolepka na stenu Kruh Hviezd Farba: černáTáto originálna samolepiaca dekorácia na stenu Kruh Hviezd sa bude pekne vynímať na stene obývacej izby, spálne či pracovne. Tieto dekorácie majú schopnosť rozprúdiť energiu a priniesť do vášho interiéru nový život. Samolepku si môžete nastrihať a jednotlivé kusy lepiť podľa vlastnej fantázie. Návod... |
14,00 € |
||
Najkoberce Fancy 904 sivý 120 cm kruhJednoduchý jednofarebný koberec so zapracovanou lesklou priadzou sa hodí do každého štýlu zariadenia. Je vyrobený z kvalitného a odolného materiálu. Vďaka vlastnostiam nenáročným na údržbu sa hodí takmer do každého obytného priestoru.▪ Výška vlasu: 12 mm▪ Celková hmotnosť: Cca 2,00 kg/m2▪ Materiál: ... |
44,90 € |
||
Najkoberce Berber 6843 romby 3D kruh béžový / krémový 120 cm kruhVyberte si z našej ponuky kobercov v rôznych farbách, veľkostiach a vzoroch. Vyrobené sú z kvalitných materiálov a nevyžadujú náročnú údržbu. Široká ponuka vám poskytuje možnosť vybrať si koberec, ktorý sa bude hodiť do štýlu interiéru, ktorý máte doma.▪ Výška vlasu: 30 mm▪ Celková hmotnosť: Cca 3,6... |
128,02 € |
||
Hrnčiarsky kruh s hlinou a farbamiPrejav svoje nadanie a vytvor si vlastnú vázu či hrnček. Nakoniec si ju ozdob podľa vlastnej fantázie. Kruh má dve rýchlosti. Plastový hrnčiarsky kruh s hlinou a farbami. Balenie obsahuje hrnčiarsky kruh (vyžaduje 2ks 1,5 V batérií typu A, ktoré nie sú súčasťou balenia), hrnčiarske pomôcky, 800g hrn... |
|
18,30 € |
|
Najkoberce LINDO krémový kruh 100 cm kruhKoberce z kolekcie LINDO budú skvelým doplnkom interiéru. Sú spojením estetiky a praktickosti. Sú vyrábané v moderných jednotných farbách, vďaka ktorým zapadnú do každého interiéru. Majú mäkké vlasy vyrobené z kvalitného materiálu, ktorý je odolný, trvácny a vhodný pre alergikov. Sú nenáročné na údr... |
27,00 € |
||
SilveAmo Strieborný prsteň se zirkónom Kruh - obvod 53 KK2F1187-17Prsteň so zirkónmi zo striebra 925, ródiovaný (ochrana proti korozívnemu černaniu), otvorený prsteň, ideálny pre tých, ktorí si nie sú istí svojou veľkosťou. Prsteň je vyhotovený v minimalistickom štýle. Buďte si istá, že s týmto prsteňom budete vždy vyzerať dokonale. |
|
35,00 € |
|
Intex Nafukovacie ihrisko kruh 48674 + 50 loptičiekJe trojkomorový bazénik s miestom pre 50 loptičiek, čo najviac ocenia tí najmenší. Je to v podstate také malé priehľadné nafukovacie ihrisko pre deti. Úrazom zabraňujú 3 vysokej kruhovej steny z priehľadného materiálu pre väčšiu bezpečnosť. Nafukovacie hračky a potreby Intex spĺňajú najprísnejšie be... |
12,25 € |
||
HydroTac Border Multisite Krytie na rany penové kruh (priemer 11,5 cm) 10ksObsah HydroTac Border Multisite Krytie na rany: HydroTac Border Multisite Krytie na rany penové kruh (priemer 11,5 cm) 10ks Charaktertistika HydroTac Border Multisite Krytie na rany: Jednorázové sterilné penové krytie, ktoré kombinuje funkciu hydratácie v mieste rany a zároveň funkciu absorpcie e... |
30,96 € |
||
Machový obraz - Kruh paradise Veľkosť rámu: 60cmObraz so stabilizovaným machom, stabilizovanými rastlinami a kvetmi" je výnimočným umeleckým dielom a zároveň dekoračným prvkom, ktorý kombinuje rôzne stabilizované prírodné materiály. Stabilizovaný mach, stabilizované rastliny a kvety sú všetky materiály, ktoré prešli procesom stabilizácie, aby si ... |
204,00 € |
||
Najkoberce BUENOS 6650 shaggy béžový kruh 200 cm kruhKolekcia kobercov BUENOS je kombináciou krásnych jednotných farieb a kvality. Zapadnú do rôznych dizajnov interiéru a dodajú teplo a útulnosť každej izbe. Sú mäkké a príjemné na dotyk. Koberce z tejto kolekcie sú vyrobené z kvalitného materiálu, ktorý zaručuje dlhú životnosť a odolnosť aj pri každod... |
157,50 € |
||
|
« Předchozí 1 … 17 18 19 20 21 … 50 Další » Nájdených viac ako 1000 výsledkov |
|||